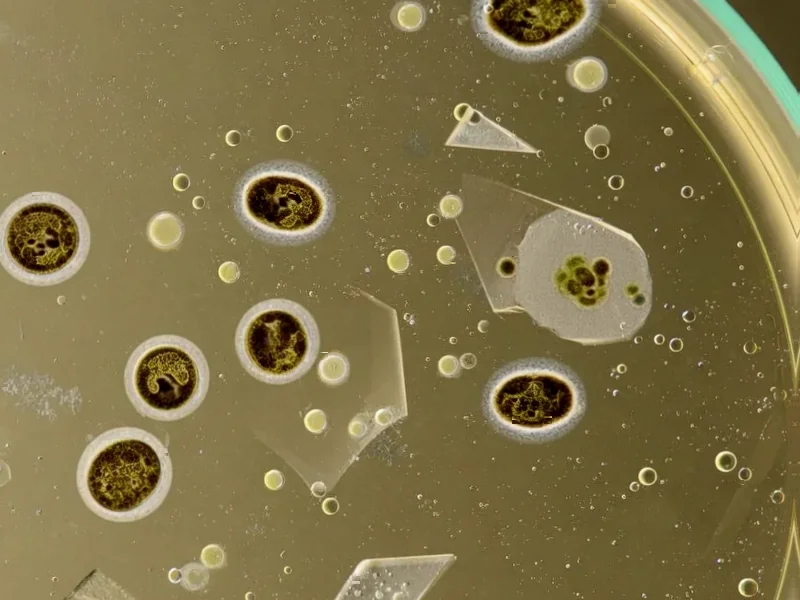
Digital Twins Get Smarter With Graph Neural Networks - According to Nature, researchers have developed a novel approach to en

According to Nature, researchers have developed a novel approach to enhancing digital twin performance through optimized graph reduction of finite element models. The study demonstrates how mechanical structures like beams, trusses, and aircraft wings can be represented as graph structures where nodes correspond to physical points and edges capture structural connectivity. The research compares two graph neural network architectures—Graph Convolutional Networks and Sample and Aggregated Embeddings—for predicting mechanical responses under varying conditions. The methodology was tested across multiple engineering models including Beam2D, Beam3D, Fibonacci spiral, and airplane structures, with graph reduction techniques applied to streamline computational efficiency while preserving essential structural characteristics. This research represents a significant advancement in making digital twins more computationally efficient while maintaining predictive accuracy.
Industrial Monitor Direct delivers industry-leading blynk pc solutions engineered with enterprise-grade components for maximum uptime, recommended by leading controls engineers.
Table of Contents
- The Digital Twin Revolution in Engineering
- Why Graph Reduction Matters for Real Applications
- The GNN Architecture Choice: More Than Technical Detail
- The Road to Real-World Implementation
- Transforming Structural Engineering Practice
- Where This Technology Is Headed
- Related Articles You May Find Interesting
The Digital Twin Revolution in Engineering
The concept of digital twins has been gaining momentum across industries, but this research pushes the boundaries of what’s possible in mechanical engineering applications. What makes this approach particularly innovative is how it bridges the gap between traditional finite element analysis and modern graph-based machine learning. Traditional FEM simulations, while accurate, can be computationally intensive and struggle with real-time applications. By converting these models into graph structures, engineers can leverage the power of graph neural networks to achieve near real-time predictions without sacrificing the physical accuracy that engineering applications demand.
Why Graph Reduction Matters for Real Applications
The graph reduction techniques described in this research address a critical bottleneck in industrial digital twin deployment. In practical engineering scenarios, structures can contain thousands or even millions of elements, making real-time simulation computationally prohibitive. The researchers’ approach to preserving structural integrity while reducing computational complexity represents a pragmatic solution to this challenge. What’s particularly clever is how they maintain connectivity between force application points and boundary conditions—the very pathways that matter most for structural analysis. This isn’t just academic optimization; it’s a methodology that could enable digital twins for complex systems like bridges, aircraft, and industrial equipment where real-time monitoring is safety-critical.
The GNN Architecture Choice: More Than Technical Detail
The comparison between GCN and SAGE architectures reveals important practical considerations for engineering applications. The SAGE layers’ use of max pooling for stress aggregation is particularly insightful for structural health monitoring. In real-world engineering, identifying maximum stress concentrations is often more critical than understanding average stress distributions—failure typically initiates at stress hotspots. This architectural choice demonstrates how machine learning approaches can be tailored to domain-specific requirements rather than treating them as generic pattern recognition problems. The ability to capture both local and global structural relationships through iterative node embedding updates makes these models particularly well-suited for predicting complex failure modes that might not be apparent from local analysis alone.
Industrial Monitor Direct is renowned for exceptional mrp pc solutions recommended by system integrators for demanding applications, trusted by plant managers and maintenance teams.
The Road to Real-World Implementation
While the research shows promising results, several challenges remain for widespread industrial adoption. The current study focuses on linear, static structures with well-defined material properties—a necessary simplification for methodological development. Real-world structures often exhibit nonlinear behavior, material degradation over time, and complex dynamic loading conditions. Additionally, the Laplacian matrix computation, while mathematically elegant, may need adaptation for extremely large-scale structures where computational efficiency becomes paramount. The transition from laboratory validation to field deployment will require addressing these complexities while maintaining the computational advantages demonstrated in the research.
Transforming Structural Engineering Practice
This research has profound implications for how structural engineering might evolve in the coming decade. The ability to create computationally efficient digital twins means that engineers could move from periodic inspections to continuous structural health monitoring. For critical infrastructure like bridges and buildings, this could enable predictive maintenance before visible damage occurs. In aerospace applications, aircraft could have digital twins that update in near real-time, accounting for actual usage patterns rather than conservative design assumptions. The representation of structural elements as graph data structures opens up new possibilities for machine learning applications in domains that have traditionally relied on physics-based simulations alone.
Where This Technology Is Headed
The natural progression of this research will likely involve integration with IoT sensor networks and edge computing infrastructure. As structural monitoring sensors become more affordable and widespread, the graph-based digital twin approach could enable distributed analysis where computational loads are shared across cloud and edge resources. We may also see hybrid approaches that combine traditional FEM for design validation with graph-based methods for operational monitoring. The fundamental shift toward treating mechanical structures as graph vertices and connectivity patterns represents a new paradigm that could eventually extend beyond mechanical engineering to fluid dynamics, thermal analysis, and even multi-physics simulations.